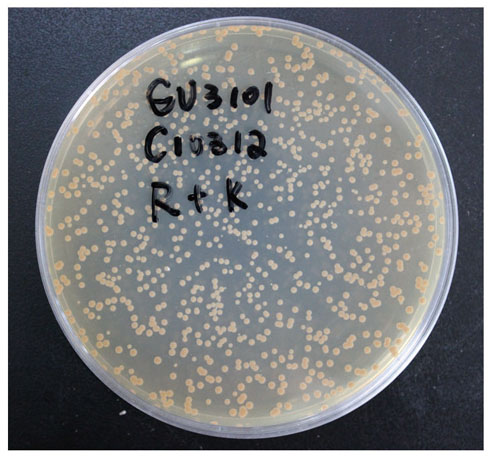

【買一送一】快速克隆解決方案——感受態(tài)細(xì)胞篇
快速克隆解決方案——感受態(tài)細(xì)胞篇
促銷時(shí)間:2018年4月1日至2018年6月30日
------------------------------------------◆ 大腸桿菌 ◆------------------------------------------
| 貨號(hào) | 名稱 | 規(guī)格 | 目錄價(jià)買一送一 | 應(yīng)用 | |
| ZC101-1 | 10×100μl | 160 | 8元/支 | 克隆常用感受態(tài) | |
| ZC101-2 | 20×100μl | 280 | 7元/支 | ||
| ZC102-1 | 10×100μl | 210 | 11元/支 | 具有T1、T5噬菌體抗性,固體平板,8-9小時(shí)可見克隆,可替代DH5α | |
| ZC102-2 | 20×100μl | 380 | 10元/支 | ||
| ZC104-1 | 10×100μl | 160 | 8元/支 | 適用于毒基因的克隆, 具有硫酸鏈霉素抗性 可替代DH5α轉(zhuǎn)化效率更高 | |
| ZC104-2 | 20×100μl | 280 | 7元/支 | ||
| ZC108-1 | 10×100μl | 300 | 15元/支 | 適用于慢病毒和逆轉(zhuǎn)病毒載體克隆 | |
| ZC108-2 | 20×100μl | 560 | 14元/支 | ||
| ZC109-1 | 10×100μl | 380 | 19元/支 | 適用于含ccDB基因的質(zhì)粒載體 | |
| ZC109-2 | 20×100μl | 680 | 17元/支 | ||
| ZC121-1 | 10×100μl | 220 | 11元/支 | 非毒蛋白的高水平表達(dá) | |
| ZC121-2 | 20×100μl | 400 | 10元/支 | ||
| ZC122-1 | 10×100μl | 250 | 13元/支 | 毒蛋白和非毒蛋白的高水平表達(dá),低背景表達(dá) | |
| ZC122-2 | 20×100μl | 460 | 12元/支 | ||
貨號(hào) | 名稱 | 規(guī)格 | 目錄價(jià) | 促銷價(jià) | 應(yīng)用 |
ZC125-1 | 10×100μl | 280 | 196 | 含有6種稀有密碼子對(duì)應(yīng)的tRNA, 適用于真核基因表達(dá) | |
ZC125-2 | 20×100μl | 500 | 380 |
-------------------------------------------◆ 農(nóng)桿菌 ◆-------------------------------------------
貨號(hào) | 名稱 | 規(guī)格 | 目錄價(jià) | 促銷價(jià) | 應(yīng)用 |
ZC141 | 20×100μl | 420 | 300 | 適用于擬南芥、煙草、玉米、土豆等植物的轉(zhuǎn)基因操作 | |
ZC142 | 20×100μl | 420 | 300 | 適用于水稻、煙草等植物的轉(zhuǎn)基因操作 | |
ZC143 | 20×100μl | 420 | 300 | 適用于菸草、番茄、煙草等植物的轉(zhuǎn)基因操作 |
-------------------------------------------◆ 菌株庫(kù) ◆-------------------------------------------
百余種菌種(大腸稀有、酵母、農(nóng)桿菌常規(guī)菌均有收錄)
專為特殊實(shí)驗(yàn)打造菌種資源庫(kù)
| 貨號(hào) | 名稱 | 效率 |
ZC131 | (常規(guī)克隆菌制備轉(zhuǎn)化效率>108cfu/ug DNA) | |
ZC132 | (常規(guī)酵母菌制備轉(zhuǎn)化效率>106cfu/ug DNA) | |
ZC134 | (常規(guī)農(nóng)桿菌制備轉(zhuǎn)化效率>103cfu/ug DNA) |
0.5ug PCAMBiA2301
轉(zhuǎn)化 100μl GV3101 全涂
更多感受態(tài):JM109、DMT、JM110、Stbl2、SURE、DH10B
詳情請(qǐng)查詢本公司官網(wǎng)或來(lái)電咨詢,歡迎選購(gòu)!!!





